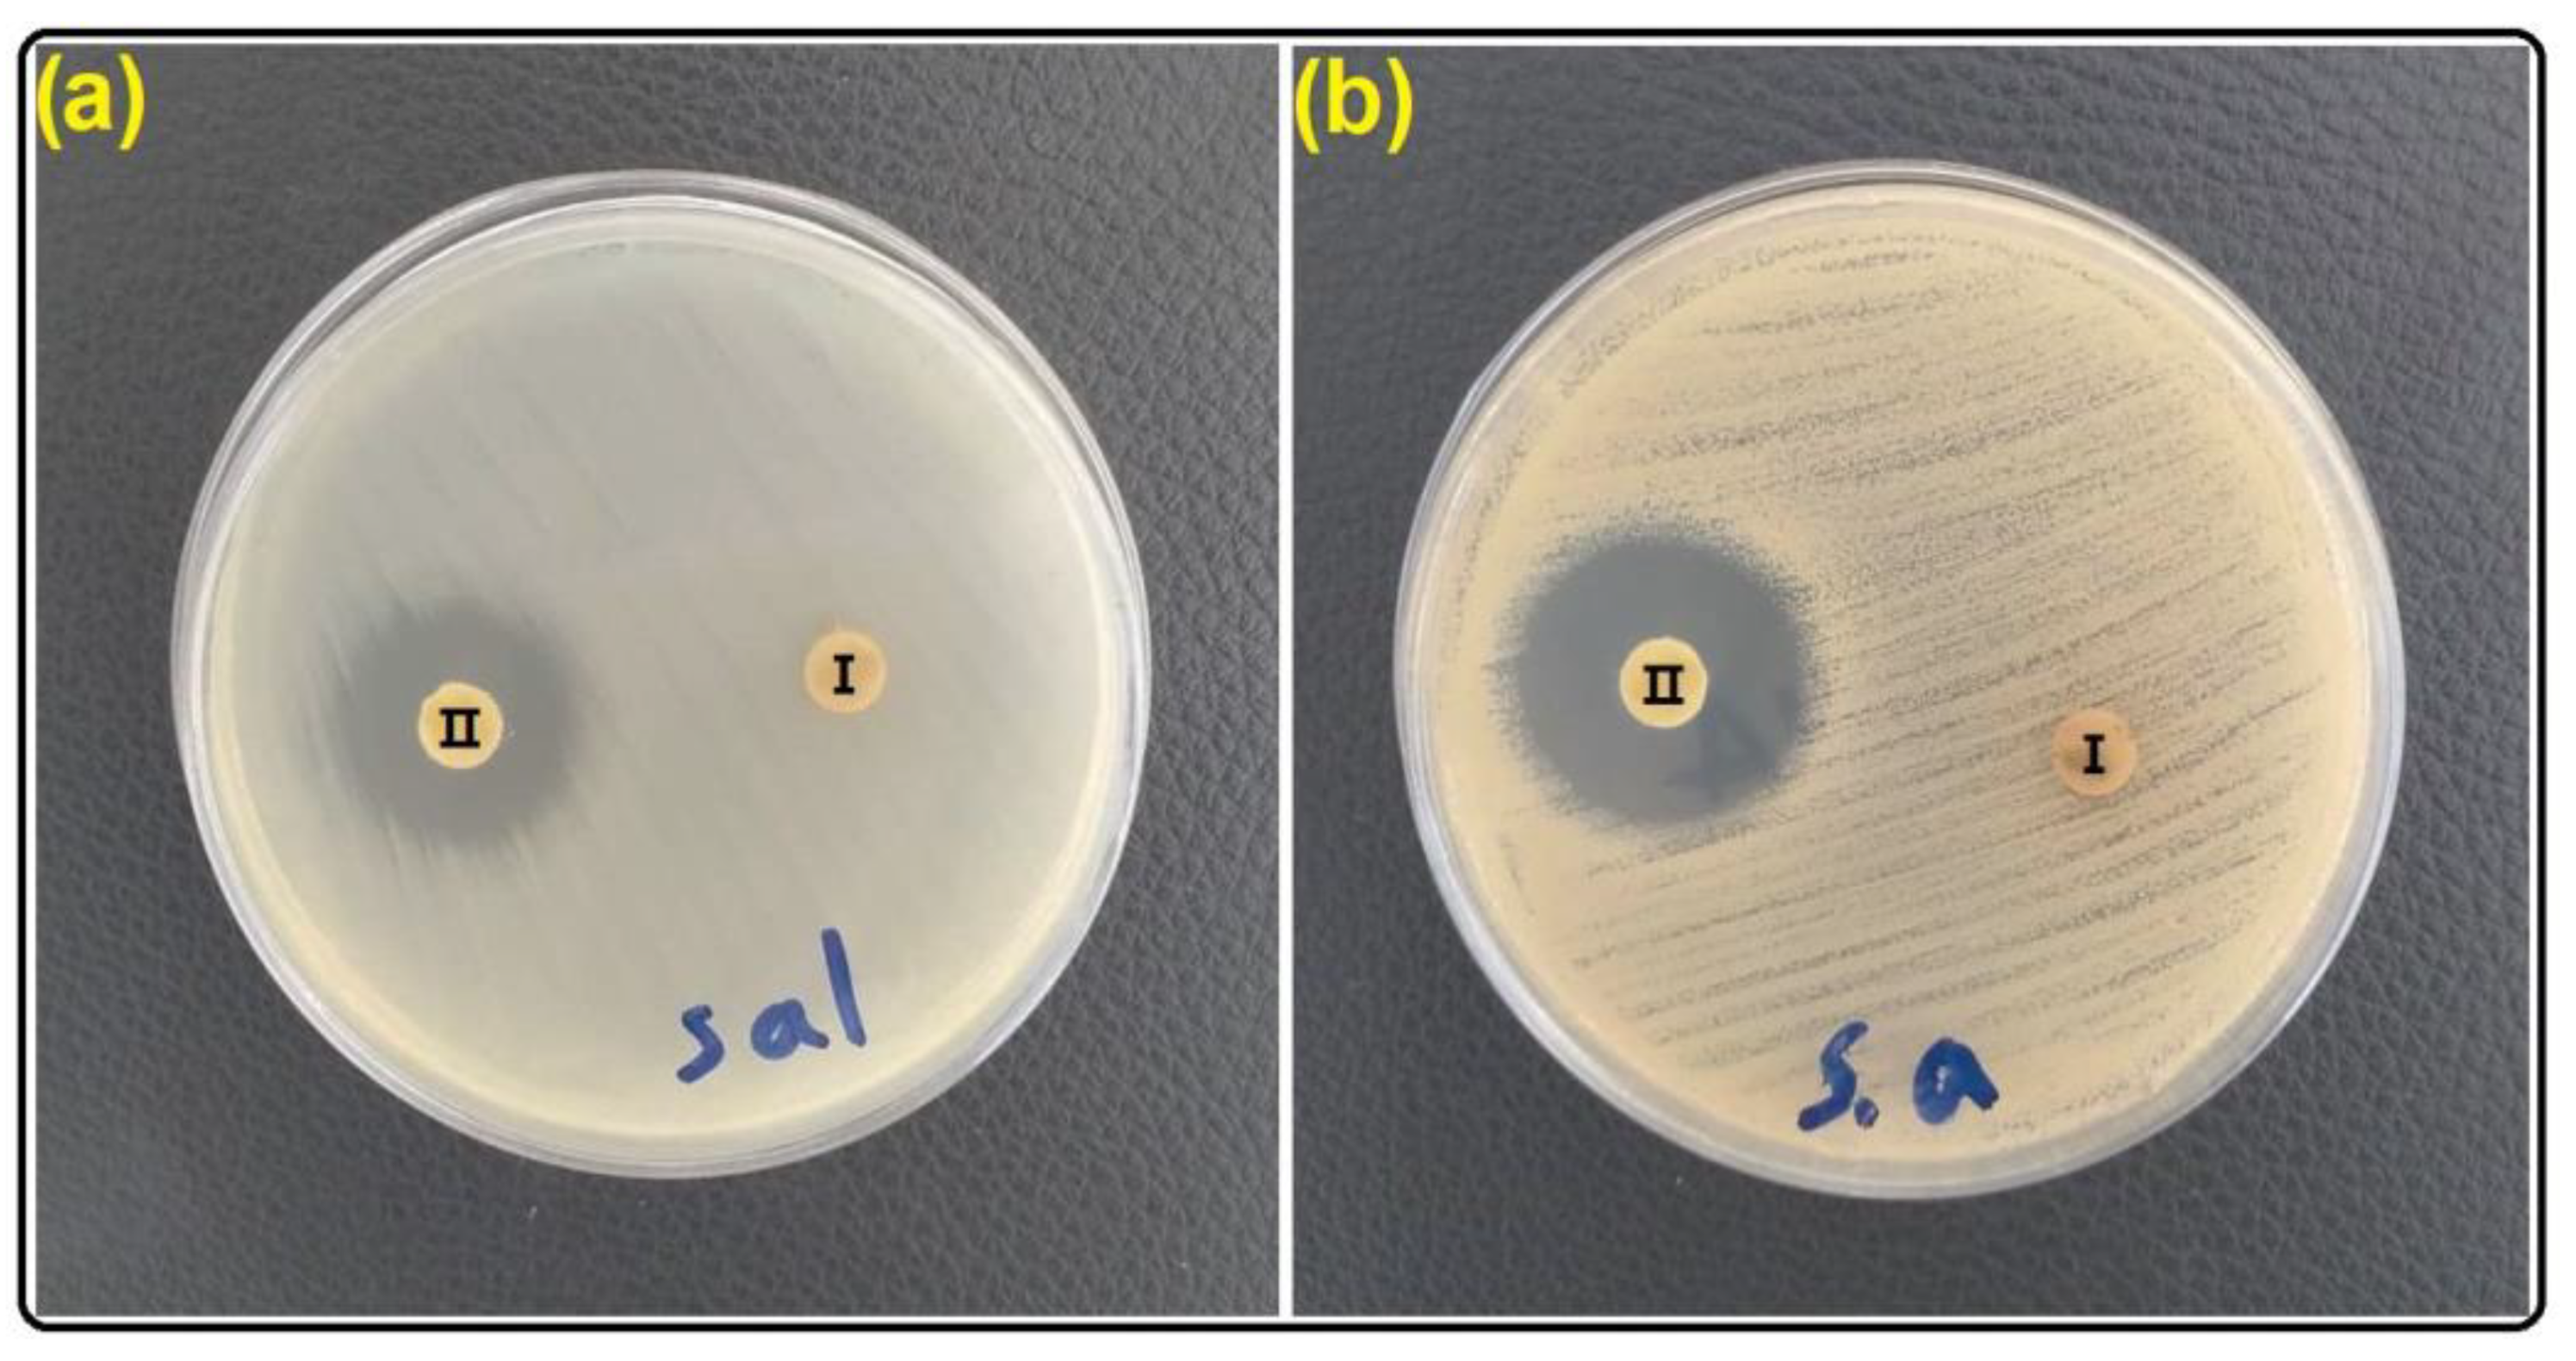
Gels 09 00490 g008 Gels 09 00490 g008

Anticorrosion and Antimicrobial Evaluation of Sol-Gel Hybrid Coatings Containing Clitoria ternatea Modified Clay
Abstract
1. Introduction
2. Results and Discussion
2.1. Evaluation of the CT-MMT
2.2. Investigation of Anticorrosion Properties
2.3. Investigation of Antimicrobial Properties
3. Conclusions
4. Materials and Methods
4.1. Materials
4.2. Modification of Na+-MMT by CT
4.3. Preparation of Coatings
4.4. The Measurements and Characterization
Author Contributions
Funding
Data Availability Statement
Conflicts of Interest
References
- Rangel-Olivares, F.R.; Arce-Estrada, E.M.; Cabrera-Sierra, R. Synthesis and characterization of polyaniline-based polymer nanocomposites as anti-corrosion coatings. Coatings 2021, 11, 653. [Google Scholar] [CrossRef]
- Edraki, M.; Sheydaei, M. Investigation of the Dual Active/Barrier Corrosion Protection, Mechanical and Thermal Properties of a Vinyl Ester Coating Doped with Ginger Modified Clay Nanoparticles. Russ. J. Appl. Chem. 2022, 95, 1481–1488. [Google Scholar] [CrossRef]
- Rodrigues, R.; Gaboreau, S.; Gance, J.; Ignatiadis, I.; Betelu, S. Reinforced concrete structures: A review of corrosion mechanisms and advances in electrical methods for corrosion monitoring. Constr. Build. Mater. 2021, 269, 121240. [Google Scholar] [CrossRef]
- Somoghi, R.; Purcar, V.; Alexandrescu, E.; Gifu, I.C.; Ninciuleanu, C.M.; Cotrut, C.M.; Oancea, F.; Stroescu, H. Synthesis of zinc oxide nanomaterials via sol-gel process with anti-corrosive effect for Cu, Al and Zn metallic substrates. Coatings 2021, 11, 444. [Google Scholar] [CrossRef]
- Ma, L.; Qiang, Y.; Zhao, W. Designing novel organic inhibitor loaded MgAl-LDHs nanocontainer for enhanced corrosion resistance. Chem. Eng. J. 2021, 408, 127367. [Google Scholar] [CrossRef]
- Refait, P.; Grolleau, A.M.; Jeannin, M.; Rémazeilles, C.; Sabot, R. Corrosion of carbon steel in marine environments: Role of the corrosion product layer. Corros. Mater. Degrad. 2020, 1, 10. [Google Scholar] [CrossRef]
- Ovari, T.R.; Szőke, Á.F.; Katona, G.; Szabó, G.S.; Muresan, L.M. Temporary Anti-Corrosive Double Layer on Zinc Substrate Based on Chitosan Hydrogel and Epoxy Resin. Gels 2023, 9, 361. [Google Scholar] [CrossRef]
- Li, J.; Bai, H.; Feng, Z. Advances in the modification of Silane-Based Sol-Gel coating to improve the corrosion resistance of magnesium alloys. Molecules 2023, 28, 2563. [Google Scholar] [CrossRef]
- Faccini, M.; Bautista, L.; Soldi, L.; Escobar, A.M.; Altavilla, M.; Calvet, M.; Domènech, A.; Domínguez, E. Environmentally friendly anticorrosive polymeric coatings. Appl. Sci. 2021, 11, 3446. [Google Scholar] [CrossRef]
- Zhang, Z.; Zhao, N.; Qi, F.; Zhang, B.; Liao, B.; Ouyang, X. Reinforced superhydrophobic anti-corrosion epoxy resin coating by fluorine-silicon-carbide composites. Coatings 2020, 10, 1244. [Google Scholar] [CrossRef]
- Wang, J.; Tang, D. Air Pollution, Environmental Protection Tax and Well-Being. Int. J. Environ. Res. Public Health 2023, 20, 2599. [Google Scholar] [CrossRef] [PubMed]
- Okesola, B.O.; Vieira, V.M.; Cornwell, D.J.; Whitelaw, N.K.; Smith, D.K. 1, 3: 2, 4-Dibenzylidene-D-sorbitol (DBS) and its derivatives–efficient, versatile and industrially-relevant low-molecular-weight gelators with over 100 years of history and a bright future. Soft Matter 2015, 11, 4768–4787. [Google Scholar] [CrossRef] [PubMed]
- Slaughter, B.V.; Khurshid, S.S.; Fisher, O.Z.; Khademhosseini, A.; Peppas, N.A. Hydrogels in regenerative medicine. Adv. Mater. 2009, 21, 3307–3329. [Google Scholar] [CrossRef] [PubMed]
- Chivers, P.R.; Smith, D.K. Shaping and structuring supramolecular gels. Nat. Rev. Mater. 2019, 4, 463–478. [Google Scholar] [CrossRef]
- Hasanzadeh, E.; Ebrahimi-Barough, S.; Mirzaei, E.; Azami, M.; Tavangar, S.M.; Mahmoodi, N.; Basiri, A.; Ai, J. Preparation of fibrin gel scaffolds containing MWCNT/PU nanofibers for neural tissue engineering. J. Biomed. Mater. Res. Part A 2019, 107, 802–814. [Google Scholar] [CrossRef] [PubMed]
- Shao, H.; He, J.; Lin, T.; Zhang, Z.; Zhang, Y.; Liu, S. 3D gel-printing of hydroxyapatite scaffold for bone tissue engineering. Ceram. Int. 2019, 45, 1163–1170. [Google Scholar] [CrossRef]
- Zhao, L.; Fu, J.; Du, Z.; Jia, X.; Qu, Y.; Yu, F.; Du, J.; Chen, Y. High-strength and flexible cellulose/PEG based gel polymer electrolyte with high performance for lithium ion batteries. J. Membr. Sci. 2020, 593, 117428. [Google Scholar] [CrossRef]
- Edraki, M.; Sheydaei, M.; Zaarei, D.; Salmasifar, A.; Azizi, B. Protective Nanocomposite Coating Based on Ginger Modified Clay and Polyurethane: Preparation, Characterization and Evaluation Anti-Corrosion and Mechanical Properties. Polym. Sci. Ser. B 2022, 64, 756–764. [Google Scholar] [CrossRef]
- Rodríguez-Alonso, L.; López-Sánchez, J.; Serrano, A.; Rodríguez de la Fuente, O.; Galván, J.C.; Carmona, N. Hybrid sol-gel coatings doped with non-toxic corrosion inhibitors for corrosion protection on AZ61 magnesium alloy. Gels 2022, 8, 34. [Google Scholar] [CrossRef]
- Merino, E.; Durán, A.; Ceré, S.; Castro, Y. Hybrid Epoxy-Alkyl Sol-Gel Coatings Reinforced with SiO2 Nanoparticles for Corrosion Protection of Anodized AZ31B Mg Alloy. Gels 2022, 8, 242. [Google Scholar] [CrossRef]
- Amirtharaj Mosas, K.K.; Chandrasekar, A.R.; Dasan, A.; Pakseresht, A.; Galusek, D. Recent advancements in materials and coatings for biomedical implants. Gels 2022, 8, 323. [Google Scholar] [CrossRef] [PubMed]
- Sfameni, S.; Rando, G.; Marchetta, A.; Scolaro, C.; Cappello, S.; Urzì, C.; Visco, A.; Plutino, M.R. Development of eco-friendly hydrophobic and fouling-release coatings for blue-growth environmental applications: Synthesis, mechanical characterization and biological activity. Gels 2022, 8, 528. [Google Scholar] [CrossRef] [PubMed]
- Necolau, M.I.; Pandele, A.M. Recent advances in graphene oxide-based anticorrosive coatings: An overview. Coatings 2020, 10, 1149. [Google Scholar] [CrossRef]
- Sheydaei, M. Sodium sulfide-based polysulfide polymers: Synthesis, cure, thermal and mechanical properties. J. Sulfur Chem. 2022, 43, 643–654. [Google Scholar] [CrossRef]
- Sheydaei, M.; Pouraman, V.; Alinia-Ahandani, E.; Shahbazi-Ganjgah, S. PVCS/GO nanocomposites: Investigation of thermophysical, mechanical and antimicrobial properties. J. Sulfur Chem. 2022, 43, 376–390. [Google Scholar] [CrossRef]
- Ollik, K.; Lieder, M. Review of the application of graphene-based coatings as anticorrosion layers. Coatings 2020, 10, 883. [Google Scholar] [CrossRef]
- Wang, Y.; Huang, Q.; Zhou, B.; Yuan, Z.; Wei, Y.; Fujita, T. Corrosion Protection of 6061 Aluminum Alloys by Sol-Gel Coating Modified with ZnLaAl-LDHs. Coatings 2021, 11, 478. [Google Scholar] [CrossRef]
- Kanninen, P.; Eriksson, B.; Davodi, F.; Buan, M.E.M.; Sorsa, O.; Kallio, T.; Lindström, R.W. Carbon corrosion properties and performance of multi-walled carbon nanotube support with and without nitrogen-functionalization in fuel cell electrodes. Electrochim. Acta 2020, 332, 135384. [Google Scholar] [CrossRef]
- Ashassi-Sorkhabi, H.; Moradi-Alavian, S.; Jafari, R.; Kazempour, A.; Asghari, E. Effect of amino acids and montmorillonite nanoparticles on improving the corrosion protection characteristics of hybrid sol-gel coating applied on AZ91 Mg alloy. Mater. Chem. Phys. 2019, 225, 298–308. [Google Scholar] [CrossRef]
- Tamalmani, K.; Husin, H. Review on corrosion inhibitors for oil and gas corrosion issues. Appl. Sci. 2020, 10, 3389. [Google Scholar] [CrossRef]
- Ionita, M.; Pandele, A.M.; Crica, L.E.; Obreja, A.C. Preparation and characterization of polysulfone/ammonia-functionalized graphene oxide composite membrane material. High Perform. Polym. 2016, 28, 181–188. [Google Scholar] [CrossRef]
- Phuangburee, T.; Solonenko, D.; Plainpan, N.; Thamyongkit, P.; Zahn, D.R.; Unarunotai, S.; Tuntulani, T.; Leeladee, P. Surface modification of graphene oxide via noncovalent functionalization with porphyrins for selective photocatalytic oxidation of alcohols. New J. Chem. 2020, 44, 8264–8272. [Google Scholar] [CrossRef]
- Dehghani, A.; Bahlakeh, G.; Ramezanzadeh, B.; Ramezanzadeh, M. Potential role of a novel green eco-friendly inhibitor in corrosion inhibition of mild steel in HCl solution: Detailed macro/micro-scale experimental and computational explorations. Constr. Build. Mater. 2020, 245, 118464. [Google Scholar] [CrossRef]
- Barbouchi, M.; Benzidia, B.; Aouidate, A.; Ghaleb, A.; El Idrissi, M. Theoretical modeling and experimental studies of Terebinth extracts as green corrosion inhibitor for iron in 3% NaCl medium. J. King. Saud. Univ. Sci. 2020, 32, 2995–3004. [Google Scholar] [CrossRef]
- Begum, A.A.S.; Vahith, R.M.A.; Kotra, V.; Shaik, M.R.; Abdelgawad, A.; Awwad, E.M.; Khan, M. Spilanthes acmella leaves extract for corrosion inhibition in acid medium. Coatings 2021, 11, 106. [Google Scholar] [CrossRef]
- Méndez, C.M.; Gervasi, C.A.; Pozzi, G.; Ares, A.E. Corrosion inhibition of aluminum in acidic solution by Ilex paraguariensis (Yerba Mate) extract as a green inhibitor. Coatings 2023, 13, 434. [Google Scholar] [CrossRef]
- Chapagain, A.; Acharya, D.; Das, A.K.; Chhetri, K.; Oli, H.B.; Yadav, A.P. Alkaloid of Rhynchostylis retusa as Green Inhibitor for Mild Steel Corrosion in 1 M H2SO4 Solution. Electrochem 2022, 3, 211–224. [Google Scholar] [CrossRef]
- Mukherjee, P.K.; Kumar, V.; Kumar, N.S.; Heinrich, M. The Ayurvedic Medicine Clitoria ternatea-From Traditional Use to Scientific Assessment. J. Ethnopharmacol. 2008, 120, 291–301. [Google Scholar] [CrossRef]
- Jamil, N.; Zairi, M.N.M.; Nasim, N.A.I.M.; Pa’ee, F. Influences of Environmental Conditions to Phytoconstituents in Clitoria ternatea (Butterfly Pea Flower)-A Review. J. Sci. Technol. 2018, 10, 208–228. [Google Scholar] [CrossRef]
- Jeyaraj, E.J.; Lim, Y.Y.; Choo, W.S. Extraction Methods of Butterfly Pea (Clitoria ternatea) Flower and Biological Activities of Its Phytochemicals. J. Food Sci. Technol. 2021, 58, 2054–2067. [Google Scholar] [CrossRef]
- Multisona, R.R.; Shirodkar, S.; Arnold, M.; Gramza-Michalowska, A. Clitoria ternatea Flower and Its Bioactive Compounds: Potential Use as Microencapsulated Ingredient for Functional Foods. Appl. Sci. 2023, 13, 2134. [Google Scholar] [CrossRef]
- Oguis, G.K.; Gilding, E.K.; Jackson, M.A.; Craik, D.J. Butterfly Pea (Clitoria ternatea), a Cyclotide-Bearing Plant with Applications in Agriculture and Medicine. Front. Plant Sci. 2019, 10, 645. [Google Scholar] [CrossRef]
- Pasukamonset, P.; Pumalee, T.; Sanguansuk, N.; Chumyen, C.; Wongvasu, P.; Adisakwattana, S.; Ngamukote, S. Physicochemical, Antioxidant and Sensory Characteristics of Sponge Cakes Fortified with Clitoria ternatea Extract. J. Food Sci. Technol. 2018, 55, 2881–2889. [Google Scholar] [CrossRef] [PubMed]
- Figueira, R.B. Hybrid sol-gel coatings for corrosion mitigation: A critical review. Polymers 2020, 12, 689. [Google Scholar] [CrossRef] [PubMed]
- Horváth, M.; Sinkó, K. Hierarchical Porous SiO2 Cryogel via Sol-Gel Process. Gels 2022, 8, 808. [Google Scholar] [CrossRef]
- Mauri, E.; Giannitelli, S.M.; Trombetta, M.; Rainer, A. Synthesis of nanogels: Current trends and future outlook. Gels 2021, 7, 36. [Google Scholar] [CrossRef]
- Jaldo Serrano, E.; López-Sánchez, J.; García-Galván, F.; Serrano, A.; Rodríguez de la Fuente, Ó.; Barranco, V.; Galván, J.C.; Carmona, N. Evaluation of Low-Toxic Hybrid Sol-Gel Coatings with Organic pH-Sensitive Inhibitors for Corrosion Protection of AA2024 Aluminium Alloy. Gels 2023, 9, 294. [Google Scholar] [CrossRef]
- Livage, J. Sol-gel processes. Curr. Opin. Solid State Mater. Sci. 1997, 2, 132–138. [Google Scholar] [CrossRef]
- Lei, Q.; Guo, J.; Noureddine, A.; Wang, A.; Wuttke, S.; Brinker, C.J.; Zhu, W. Sol-gel-based advanced porous silica materials for biomedical applications. Adv. Funct. Mater. 2020, 30, 1909539. [Google Scholar] [CrossRef]
- Jaafar, A.; Hecker, C.; Árki, P.; Joseph, Y. Sol-gel derived hydroxyapatite coatings for titanium implants: A review. Bioengineering 2020, 7, 127. [Google Scholar] [CrossRef]
- Mistry, B.D. A Handbook of Spectroscopic Data; Oxford Book Company: Jaipur, India, 2009; Volume 600. [Google Scholar]
- Lakshmi, C.H.N.D.; Raju, B.P.; Madhavi, T.; Sushma, N.J. Identification of bioactive compounds by FTIR analysis and in vitro antioxidant activity of Clitoria ternatea leaf and flower extracts. Indo Am. J. Pharm. 2014, 4, 3894–3903. [Google Scholar]
- Mathai, R.V.; Mitra, J.C.; Sar, S.K. Phytochemical and qualitative characterization of leaves of some noteworthy medicinal plants of Chhattisgarh, India. Rasayan J. Chem. 2021, 14, 1423–1434. [Google Scholar] [CrossRef]
- Ghazi, A.; Ghasemi, E.; Mahdavian, M.; Ramezanzadeh, B.; Rostami, M. The application of benzimidazole and zinc cations intercalated sodium montmorillonite as smart ion exchange inhibiting pigments in the epoxy ester coating. Corros. Sci. 2015, 94, 207–217. [Google Scholar] [CrossRef]
- Marchante, V.; Marcilla, A.; Benavente, V.; Martínez-Verdú, F.M.; Beltran, M.I. Linear low-density polyethylene colored with a nanoclay-based pigment: Morphology and mechanical, thermal, and colorimetric properties. J. Appl. Polym. Sci. 2013, 129, 2716–2726. [Google Scholar] [CrossRef]
- Izadi, M.; Shahrabi, T.; Mohammadi, I.; Ramezanzadeh, B. Synthesis of Impregnated Na+-Montmorillonite as an Eco-Friendly Inhibitive Carrier and its Subsequent Protective Effect on Silane Coated Mild Steel. Prog. Org. Coat. 2019, 135, 135–147. [Google Scholar] [CrossRef]
- Mishra, A.; Verma, C.; Lgaz, H.; Srivastava, V.; Quraishi, M.A.; Ebenso, E.E. Synthesis, characterization and corrosion inhibition studies of N-phenyl-benzamides on the acidic corrosion of mild steel: Experimental and computational studies. J. Mol. Liq. 2018, 251, 317–332. [Google Scholar] [CrossRef]
- Hamidon, T.S.; Ishak, N.A.; Hussin, M.H. Enhanced corrosion inhibition of low carbon steel in aqueous sodium chloride employing sol-gel-based hybrid silanol coatings. J. Sol-Gel Sci. Technol. 2021, 97, 556–571. [Google Scholar] [CrossRef]
- Alibakhshi, E.; Ramezanzadeh, M.; Haddadi, S.A.; Bahlakeh, G.; Ramezanzadeh, B.; Mahdavian, M. Persian Liquorice extract as a highly efficient sustainable corrosion inhibitor for mild steel in sodium chloride solution. J. Cleaner Prod. 2019, 210, 660–672. [Google Scholar] [CrossRef]
- Shao, F.; Yang, K.; Zhao, H.; Liu, C.; Wang, L.; Tao, S. Effects of inorganic sealant and brief heat treatments on corrosion behavior of plasma sprayed Cr2O3-Al2O3 composite ceramic coatings. Surf. Coat. Technol. 2015, 276, 8–15. [Google Scholar] [CrossRef]
- Dehghani, A.; Bahlakeh, G.; Ramezanzadeh, B.; Mofidabadi, A.H.J. Improvement of the anti-corrosion ability of a silane film with β-cyclodextrin-based nanocontainer loaded with L-histidine: Coupled experimental and simulations studies. Prog. Org. Coat. 2021, 157, 106288. [Google Scholar] [CrossRef]
- Nikpour, S.; Naderi, R.; Mahdavian, M. Fabrication of silane coating with improved protection performance using Mentha longifolia extract. J. Taiwan Inst. Chem. Eng. 2018, 88, 261–276. [Google Scholar] [CrossRef]
- Salmasifar, A.; Edraki, M.; Alibakhshi, E.; Ramezanzadeh, B.; Bahlakeh, G. Theoretical design coupled with experimental study of the effectiveness of the inhibitive molecules based on Cynara scolymus L. extract toward chloride-induced corrosion of steel. J. Mol. Liq. 2021, 332, 115742. [Google Scholar] [CrossRef]
- Edraki, M.; Zaarei, D. Azole derivatives embedded in montmorillonite clay nanocarriers as corrosion inhibitors of mild steel. Int. J. Miner. Metall. Mater. 2019, 26, 86–97. [Google Scholar] [CrossRef]
- Sheydaei, M.; Shahbazi-Ganjgah, S.; Alinia-Ahandani, E.; Sheidaie, M.; Edraki, M. An overview of the use of plants, polymers and nanoparticles as antibacterial materials. Chem. Rev. Lett. 2022, 5, 207–216. [Google Scholar] [CrossRef]
- Sheydaei, M.; Pouraman, V.; Edraki, M.; Alinia-Ahandani, E. and Asadi-Sadeh, S.M. Targeted application of GO to improve mechanical and thermal properties of PVCS/RS composites. Phosphorus Sulfur Silicon Relat. Elem. 2023, 198, 345–353. [Google Scholar] [CrossRef]
- Lishchynskyi, O.; Shymborska, Y.; Stetsyshyn, Y.; Raczkowska, J.; Skirtach, A.G.; Peretiatko, T.; Budkowski, A. Passive antifouling and active self-disinfecting antiviral surfaces. Chem. Eng. J. 2022, 446, 137048. [Google Scholar] [CrossRef]
- Daglia, M. Polyphenols as antimicrobial agents. Curr. Opin. Biotechnol. 2012, 23, 174–181. [Google Scholar] [CrossRef]
- Marhamati, F.; Mahdavian, M.; Bazgir, S. Corrosion mitigation of mild steel in hydrochloric acid solution using grape seed extract. Sci. Rep. 2021, 11, 18374. [Google Scholar] [CrossRef]

| Sample | Icorr (μA·cm−2) | Ecorr (mV/SCE ) | βα (mV·dec−1) | βc (mV·dec−1) | C.R (mm·y−1) |
|---|---|---|---|---|---|
| Blank | −314.13 | −741.68 | 187.24 | 367.48 | 98.54 |
| SGC | −61.24 | −786.41 | 96.87 | 60.38 | 23.70 |
| SGC/1.5% CT-MMT | −31.59 | −651.34 | 58.69 | 43.10 | 9.43 |
| SGC/3% CT-MMT | −17.19 | −629.22 | 43.61 | 33.64 | 6.25 |
| Sample | RS (Ω·cm2) | Rct (Ω·cm2) | CPEdl Yo,dl (mΩ−1·cm−2) ndl | Cdl (μF·cm2) | CPEf Yo,f (mΩ−1·cm−2) nf | Rf (Ω·cm2) | IE (%) | log |z| (Ω·cm2) | ||
|---|---|---|---|---|---|---|---|---|---|---|
| Blank | 27.41 | 715 | 0.82 | 0.71 | 879 | - | - | - | - | 2.6 |
| SGC | 23.87 | 1866 | 0.65 | 0.77 | 845 | 0.94 | 0.67 | 218 | 61.7 | 3.1 |
| SGC/1.5% CT-MMT | 25.34 | 3459 | 0.38 | 0.79 | 636 | 0.62 | 0.69 | 359 | 79.3 | 3.4 |
| SGC/3% CT-MMT | 27.79 | 5106 | 0.09 | 0.86 | 95 | 0.28 | 0.85 | 687 | 86 | 3.8 |
| ** MBC | ** MIC | * DD | Microorganism |
|---|---|---|---|
| - a | - a | - a | Staphylococcus aureus (ATCC 29737) |
| 1000 b | 500 b | 9 b | |
| - a | - a | - a | Salmonella paratyphi-A serotype (ATCC 5702) |
| 2000 b | 1000 b | 6 b |
Disclaimer/Publisher’s Note: The statements, opinions and data contained in all publications are solely those of the individual author(s) and contributor(s) and not of MDPI and/or the editor(s). MDPI and/or the editor(s) disclaim responsibility for any injury to people or property resulting from any ideas, methods, instructions or products referred to in the content. |
© 2023 by the authors. Licensee MDPI, Basel, Switzerland. This article is an open access article distributed under the terms and conditions of the Creative Commons Attribution (CC BY) license (https://creativecommons.org/licenses/by/4.0/).
Share and Cite
Sheydaei, M.; Edraki, M.; Radeghi Mehrjou, S.M. Anticorrosion and Antimicrobial Evaluation of Sol-Gel Hybrid Coatings Containing Clitoria ternatea Modified Clay. Gels 2023, 9, 490. https://doi.org/10.3390/gels9060490
Sheydaei M, Edraki M, Radeghi Mehrjou SM. Anticorrosion and Antimicrobial Evaluation of Sol-Gel Hybrid Coatings Containing Clitoria ternatea Modified Clay. Gels. 2023; 9(6):490. https://doi.org/10.3390/gels9060490
Chicago/Turabian StyleSheydaei, Milad, Milad Edraki, and Seyyed Mehdi Radeghi Mehrjou. 2023. "Anticorrosion and Antimicrobial Evaluation of Sol-Gel Hybrid Coatings Containing Clitoria ternatea Modified Clay" Gels 9, no. 6: 490. https://doi.org/10.3390/gels9060490
APA StyleSheydaei, M., Edraki, M., & Radeghi Mehrjou, S. M. (2023). Anticorrosion and Antimicrobial Evaluation of Sol-Gel Hybrid Coatings Containing Clitoria ternatea Modified Clay. Gels, 9(6), 490. https://doi.org/10.3390/gels9060490
